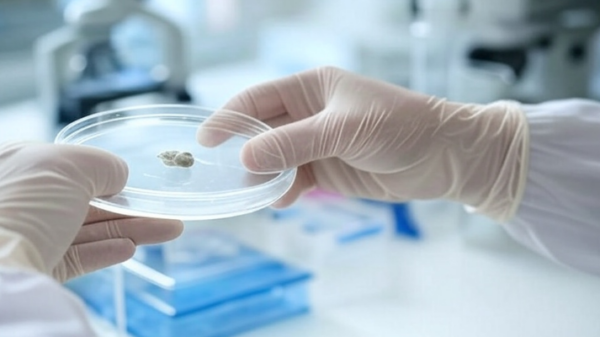
doença laboratório
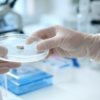
doença laboratório

O QUE ESTÁ PROCURANDO
All posts tagged "Congo"
Mundo
Um número desconhecido de pessoas foi morto e vários outros ficaram feridos depois que as forças de paz das Nações Unidas abriram fogo em...
Mundo
Pelo menos 15 pessoas morreram e cerca de 50 ficaram feridas no segundo dia de protestos contra as Nações Unidas na cidade de Goma, no leste da República Democrática do...
Mundo
A Organização Mundial da Saúde (OMS) informou nesta segunda-feira (18) que foram detectados três novos casos de ebola na República Democrática Oriental do Congo....
Mundo
Um caso de ebola foi confirmado na República Democrática do Congo (RDC), apenas cinco meses após a declaração do fim da última epidemia da doença no...
Mundo
Pelo menos 60 pessoas morreram e centenas estão desaparecidas após o naufrágio de uma embarcação no rio Congo, na parte oeste da República Democrática...